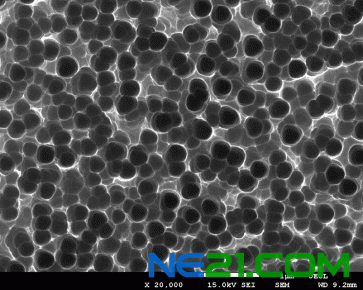
黑硅表面微观结构,表面大量的纳米孔可以增加光吸收

日前,中科院微电子研究所在多晶黑硅太阳能电池研究方面获得重要突破。
黑硅是一种低反射率的硅材料,和常规的硅材料相比,它具有超强的吸收光线的能力,可用于太阳能电池产业。微电子所微电子设备研究室(八室)夏洋研究员带领的研究团队原创性地提出利用等离子体浸没离子注入技术制备黑硅材料。该团队利用自行研制的等离子体浸没离子注入机(国家自然科学基金委、中科院装备项目、方向性项目支持)制备了多种微观结构的黑硅材料,在可见光波段黑硅的平均反射率为0.5%,与飞秒激光制备黑硅的反射率相当。同时该工艺适应大批量制备,成本低,生产效率高。
相关科研论文发表在Solar Energy、Energy Procedia、Journal of Electron Spectroscopy and Related Phenomena、《物理学报》等期刊上,已申请专利30余项。
通过对黑硅结构进行优化,并且对生产线电池配套工艺进行改进,在全国产设备生产线研发出多晶黑硅太阳能电池(156mm×156mm,多晶),批量平均效率高达17.46%,最高可到17.65%。
|
索比光伏网 https://news.solarbe.com/201205/10/256112.html

